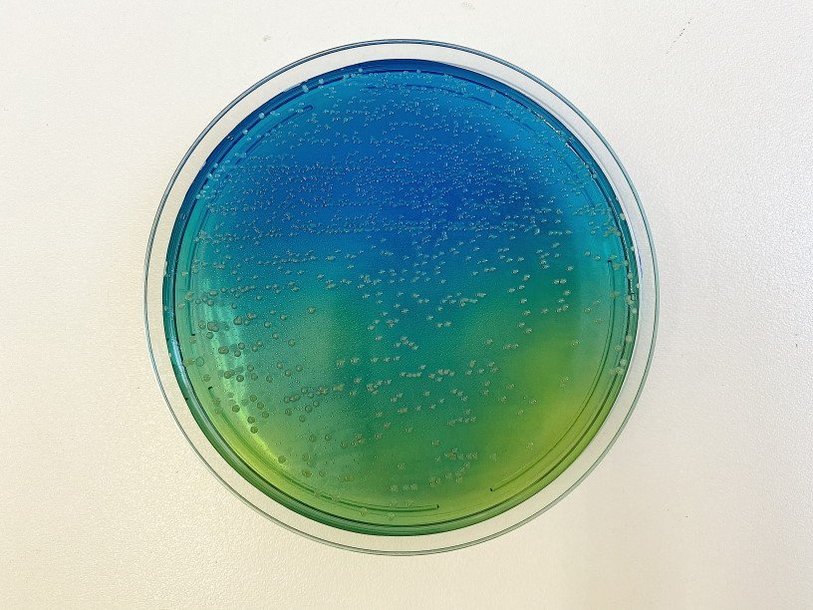

Екатерина Беленко: Промикробы: Универсальная кислота
Питательная среда в чашке Петри Фото: Екатерина Беленко
Питательная среда в чашке Петри Фото: Екатерина Беленко Мои постоянные читатели уже знают о существовании очень многих питательных сред, но сегодня я расскажу еще об одной. Эта питательная среда называется «цитратный агар Симмонса». Она плотная (антагонист жидкой), а все благодаря агар-агару, как вы уже знаете. Эту среду разливают по чашкам Петри, как на фото, и по пробиркам, но с небольшой хитростью. Пробирку с еще горячей расплавленной средой помещают на наклонный штатив и получают скошенный агар, или косяк. Да-да, я не шучу, именно так это и называется. Посев на скошенный агар можно проводить рассевом по поверхности либо глубоким уколом. Но давайте попробуем разобраться, в чем же заключается диагностическая сила этой питательной среды.
⠀
Цитратный агар Симмонса используется для идентификации микроорганизмов (чаще всего энтеробактерий) по их способности к утилизации цитрата как единственного источника углерода, а солей аммония — в качестве единственного источника азота. Так делать умеют не все микробики. Среди энтеробактерий подобными свойствами обладают следующие роды: Enterobacter, Klebsiella, Serratia, Citrobacter, а также некоторые виды сальмонелл (S. schottumelleri, S. typhimurium, S. arizona и др.). Escherichia spp., Shigella spp., Salmonella typhi и Salmonella paratyphi на этой среде расти не способны.
⠀
Не только клебсиеллы и другие малыши любят перекусить цитратом, но и мы с вами. Ведь цитрат натрия — это натриевая соль лимонной кислоты Na3C6H5O7, имеющая средневыраженный солено-кислый вкус. Цитрат натрия применяется в основном как специя, придающая особый вкус, или как консервант (пищевая добавка E331). Как вкусовая добавка цитрат натрия входит в состав множества газированных напитков со вкусом лимона или лайма, а также в состав энергетических напитков. Кроме того является солью-плавителем, используемой при производстве плавленого сыра с самого момента его изобретения в 1911 году. И еще множество различных применений для одной соли.
⠀
Но вернемся к еде для микробов. Не все из них любят цитрат натрия и гидрофосфат аммония. Но те, кто любит, радостно растут и размножаются на агаре Симмонса. Микроорганизмы в ходе размножения на среде продуцируют щелочные продукты, которые способствуют изменению цвета индикатора с зеленого на синий. Это возможно благодаря еще одному компоненту питательной среды — индикатору рН под гордым названием бромтимоловый синий. И, соответственно, если цитрат не используется в качестве пищи, цвет питательной среды не меняется — отрицательная реакция.
⠀
В пробирках этот агар используется во многих исследованиях, а в чашках Петри — только для посева кала при проведении анализа на дисбактериоз кишечника. Такая вот съедобная среда для самого неаппетитного анализа.
Смотрите также: Екатерина Беленко Промикробы: Свой среди чужих Екатерина Беленко Промикробы: Коррозия металла Екатерина Беленко Промикробы: Кончится пленка Екатерина Беленко Промикробы: Броня крепка